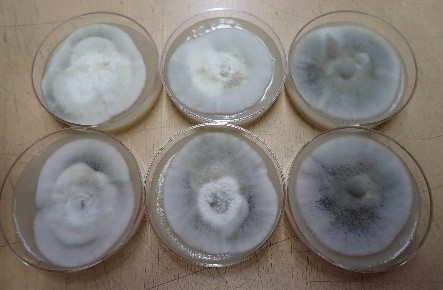
いもち病菌

作物研究センターでは、病気の原因となる菌を育てて、安全に病気を再現することで効果的な防除方法を探っています。菌の種類ごとにいろんな培地(生育環境)を使って育てます。
水稲の病害

もみ枯細菌病菌:糖類など必要な成分を溶かした寒天で固めた培地を使って増やします。
-
-
いもち病菌:オートミールを煮て寒天で固めた培地で胞子を作って増やします。
-
-

紋枯病菌:もみ殻とふすま(小麦の表皮と胚芽)を混ぜた培地で増やします。
大豆の病害

紫斑病菌:大豆を砕いた培地を使って増やします。
-
黒根腐病菌:バーミキュライトとふすまを混ぜた培地で増やします(左)。
- 大きな袋で大量(1袋に1kg)に培養することもあります(右)。
小麦の病害

赤かび病:胞子を増やすための緑豆の煮汁培地(左)。
- ほ場で試験する場合はトウモロコシ粒を使って増やして圃場に散布します(右)。
このように、病気の種類や研究の目的に応じていろんな培地を使って菌を育てます。